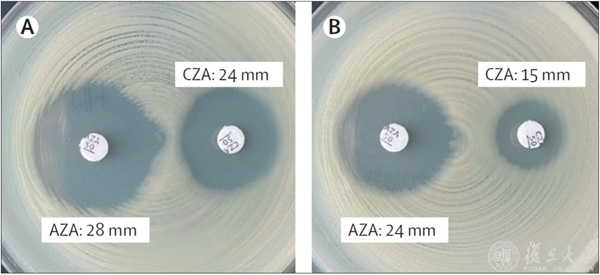

上新啦!复旦大学科研团队近期又取得了数项成果和突破。小编为你整理了2022年6月部分科研成果,快一起来看看吧!
数学物理领域
1.现代物理研究所马余刚院士团队在核物质液气相变研究中取得新进展

近日,现代物理研究所马余刚院士团队一项核物理领域的研究成果,以“在核物质液气相变区域中碎片形成对粘滞系数的影响” (Impact of fragment formation on shear viscosity in the nuclear liquid-gas phase transition region)为题,被遴选为“编辑推荐”的亮点文章发表在核物理学领域的国际著名期刊Physical Review C上。
2.现代物理研究所粒子物理研究团队参与的北京谱仪III实验开创新方法探索正反物质不对称性

复旦大学参与的北京谱仪III合作组(BESIII Collaboration)在世界上首次利用处于量子纠缠的正反科西超子对的级联衰变,成功地把导致正反物质不对称的弱作用力从强作用力中分离出来,这一创新实验方法为研究物质和反物质不对称性提供了极其灵敏的实验探针,引起了领域内国际同行的高度关注。该研究成果于6月2日发表于Nature杂志。复旦大学现代物理研究所粒子物理研究团队于2017年加入BESIII合作组,在实验的运行取数、物理分析中都发挥了重要作用。团队成员严亮青年研究员在该研究中做出重要贡献,按照BESIII合作组署名规则,文章以BESIII Collaboration署名。
新闻链接:https://news.fudan.edu.cn/2022/0603/c4a131534/page.htm
3.物理系顾嘉荫课题组在有效场论正定性的研究中取得重要进展

近日,物理系顾嘉荫青年研究员与其合作者的研究突破性地指出,对于正负电子湮灭产生双光子的过程,新物理贡献的领头阶效应出现在8维算符的系数上,而此系数受到正定性的限制。研究进一步对未来轻子对撞机上双光子过程测量的前景进行了预研。该工作于6月29日以“Unambiguously Testing Positivity at Lepton Colliders”为题发表于《物理评论快报》[Phys.Rev.Lett. 129, 011805 (2022)]。
新闻链接:https://mp.weixin.qq.com/s/kFBOU1uhSnZlbZjFhf8fYA
化学材料领域
1.《国家科学评论》特邀化学系赵东元院士编辑出版“二维功能材料”专题

近期,《国家科学评论》(National Science Review,NSR)出版了“二维功能材料”专题,由中国科学技术大学谢毅院士和复旦大学赵东元院士担任特邀编辑。该专题收录了11篇论文,内容涵盖了二维功能材料最先进的合成和应用进展。
新闻链接:https://mp.weixin.qq.com/s/OVI66mhLNksPizfso78TRQ
2.化学系邓春晖教授团队通过房水代谢分析实现精确区分不同高危病因型白内障

最近,化学系邓春晖教授团队联合中山医院孙念荣副研究员,眼耳鼻喉科医院蒋永祥教授一起针对以上问题构建了一种基于MALDI质谱的层状二元共离子体辅助房水代谢分析平台,用于对白内障进行潜在的病因学分型和检测。仅需要1 μL的房水样品,即精准、快速、高通量地实现对年龄相关性白内障(ARC)、糖尿病状态白内障(CDM)和高度近视状态白内障(CHM)的检测。相关结果近期发表在Advanced Science上。
新闻链接:
https://chemistry.fudan.edu.cn/e1/6c/c21871a450924/page.htm
3.航空航天系徐凡课题组揭示光取向调控水膜系统超灵敏起皱

近期,复旦大学航空航天系徐凡课题组与天津大学鲁从华、李奇峰、清华大学曹艳平课题组开展多学科交叉研究,将“液体”基底带来的高灵敏性与偶氮苯基团具有的独特光响应性巧妙结合,构建了一种基于偶氮聚合物漂浮膜、偏振光触发、时空可控、超灵敏的动态起皱体系。相关成果以“Polarization-Dependent Ultrasensitive Dynamic Wrinkling on Floating Films Induced by Photo-Orientation of Azopolymer”为题作为Hot Paper发表于国际化学顶级期刊Angew. Chem. Int. Ed.(2022, e202203715)。
新闻链接:
https://aero-mech.fudan.edu.cn/e8/58/c17627a452696/page.htm
信息领域
1.信息学院他得安教授/王威琪教授团队实现超快超分辨率超声微血流成像和脑功能成像

近日,智慧医疗超声实验室他得安教授和王威琪教授团队在超高分辨率血流提取与脑功能成像方法方面取得了技术突破,实现了大鼠脑功能区的精准成像(时间分辨率<1 ms)。成果以Randomized Spatial Downsampling based Cauchy-RPCA Clutter Filtering for High-Resolution Ultrafast Ultrasound Microvasculature Imaging and Functional Imaging为题发表于国际超声权威期刊IEEE Trans UFFC上。
2.微电子学院陈琳团队提出了新型超低功耗柔性光电双调制神经突触器件

近日,复旦大学微电子学院陈琳教授团队在Nano Letters发表了题为“Ultralow Power Wearable Organic Ferroelectric Device for Optoelectronic Neuromorphic Computing”的文章,该研究提出了一种新型可穿戴有机铁电人工突触,它具有两种调制模式(光调制和电调制)。这为超低功耗人工智能系统的构建和未来可穿戴设备的发展提供了新的途径。
新闻链接:
https://mp.weixin.qq.com/s/TGs-opr5mjgxKdk3BwEA7A
3.微电子学院卢红亮课题组在柔性氧化镓光电探测器方面取得重要研究进展

近日,复旦大学微电子学院卢红亮教授团队首次在聚酰亚胺(PI)基板上制备了全柔性的高性能β-Ga2O3光电晶体管,实现了超灵敏的深紫外光探测率,填补了β-Ga2O3基柔性深紫外探测领域的空白。相关工作以“High responsivity and flexible deep-UV phototransistor based on Ta-doped β-Ga2O3”为题发表于npj Flexible Electronics杂志上。
新闻链接:
https://mp.weixin.qq.com/s/mxwmrlViyy5ifPO_Y-dRkw
4.微电子学院包文中课题组提出了适用于二维半导体的集成电路顶栅工艺方法

通过借鉴硅基集成电路先进制程中的“high-k绝缘层/金属栅工艺”工艺,微电子学院包文中课题组提出了简便的非破坏性掺杂的顶栅晶体管电学性能调控工艺方法,通过利用具有不同功函数的金属栅极和电偶极子效应,设计了一种Al/Au双金属层栅极结构,在二维半导体晶圆上实现了对晶体管阈值电压的可控调节。近日,此工作以“Engineering top gate stack for wafer-scale integrated circuit fabrication based on two-dimensional semiconductors”为题发表在国际期刊ACS Applied Material & Interfaces上。
新闻链接:
https://mp.weixin.qq.com/s/LAng8o3wzjOhYcqbmjzckg
5.计算机科学技术学院肖仰华教授团队提出归纳式的常识知识获取方法

近日,复旦大学计算机科学技术学院肖仰华教授团队提出了一种利用概念指引从实例知识进行归纳而获取常识的方法,并将其成功应用于以动词为核心的隐性常识获取任务中。该研究成果以“VoCSK: Verb-oriented Commonsense Knowledge Mining with Taxonomy-guided Induction”为题在线发表于国际上极具影响力Artificial Intelligence期刊。相关资料显示,这是该期刊创刊以来,首次由上海科研机构作独立完成的首篇论文,也是复旦大学首次以第一作者单位或通讯作者单位在该期刊上录用的首篇文章。
新闻链接:https://cs.fudan.edu.cn/e3/6c/c24256a451436/page.htm
6.计算机科学技术学院王新教授、周扬帆副教授团队提出人工智能基础软件库测试方法

近日,复旦大学计算机科学技术学院王新教授、周扬帆副教授带领博士生顾嘉臻、硕士生罗旭川针对新兴人工智能软件系统测试方法的不足,提出了一种针对人工智能基础软件库的新测试方法,该方法提出构造多样化的神经网络作为测试用例,突破了目前主流方法测试效率低下的技术瓶颈,在TensorFlow等关键深度学习基础软件库新发现了39个之前未知的深度学习运算故障;该研究以“Muffin: Testing Deep Learning Libraries via Neural Architecture Fuzzing“为题发表于软件工程旗舰会议IEEE/ACM International Conference on Software Engineering(ICSE 2022)上。
新闻链接:https://cs.fudan.edu.cn/e1/16/c24256a450838/page.htm
生命医学领域
1.人类表型组研究院金力院士、附属中山医院邹云增教授与基础医学院李立亮副教授团队合作揭示抗精神病药心脏毒性的新机制

6月24日,复旦大学遗传工程国家重点实验室、复旦大学人类表型组研究院、复旦大学上海医学院金力院士与上海市心血管病研究所、复旦大学附属中山医院邹云增教授与复旦大学基础医学院李立亮副教授团队合作,在Nature旗下Signal Transduction and Targeted Therapy杂志上发表了题为“CB1R-stabilized NLRP3 inflammasome drives antipsychotics cardiotoxicity”的研究论文,鉴定了1型大麻素受体(CB1R)作为抗精神病药的心肌直接膜受体,介导了多种抗精神病药引起的心肌焦亡与毒性过程。
2.生命科学学院麻锦彪团队合作解析果蝇Dicer-2结合双链RNA加工生成siRNA的分子机制,成果登上《自然》主刊

2022年6月29日,复旦大学生命科学院麻锦彪团队与清华大学王宏伟团队在《自然》杂志主刊(Nature)在线发表了题为Structural insights into dsRNA processing by Drosophila Dicer-2–Loqs-PD(《果蝇Dicer-2和Loqs-PD复合物在双链RNA加工过程的结构深入解析》)的文章,该研究通过解析了包括Dicer-2-Loqs-PD单独蛋白,以及Dicer-2–Loqs-PD在有无ATP的情况下结合dsRNA的6套冷冻电镜结构(图1),结合生化实验分析,首次揭示了Dicer-2-Loqs-PD复合物结合并切割双链RNA产生siRNA的依赖ATP的加工循环分子机制(图2),解决了20多年困扰小干扰RNA领域的关键科学问题。
新闻链接:https://news.fudan.edu.cn/2022/0630/c4a131790/page.htm
3.生命科学学院徐书华团队发布族群特异性参考基因组应用分析流程

近期,复旦大学生命科学学院徐书华团队在Cell Press旗下学术期刊Star Protocols在线发表了题为“A protocol for applying a population-specific reference genome assembly to population genetics and medical studies”的方法技术论文,公布了基于族群特异性参考基因组开展群体遗传学和医学遗传学研究的分析流程。
新闻链接:https://life.fudan.edu.cn/ca/fa/c28140a445178/page.htm
4.基础医学院及生物医学研究院储以微、刘荣花团队聚焦B淋巴细胞揭秘肠癌免疫逃逸新机制

2022年6月3日,复旦大学生物医学研究院储以微、刘荣花团队在Immunity杂志上发表了题为Leucine tRNA Synthase-2 Expressing B cells Contribute to Colorectal Cancer Immunoevasion的研究论文。团队利用单细胞技术分析了结直肠癌(Colorectal cancer, CRC)不同阶段的肿瘤浸润B细胞,发现一群高表达亮氨酸tRNA合成酶2(LARS2)的B细胞新亚群(LARS B)。这群LARS B不仅具有TGF-β1主导的调节性特征,而且具有亮氨酸营养偏好。
新闻链接:https://news.fudan.edu.cn/2022/0604/c5a131536/page.htm
5.生物医学研究院陆豪杰/张莹团队开发高通量位点特异性糖蛋白质标志物研究新方法

针对位点特异性糖肽高通量定性定量分析的挑战,生物医学研究院陆豪杰团队提出了一种高通量位点特异性糖蛋白组的研究方法(HTiGQs),近日以“High-throughput site-specific N-glycoproteomics reveals glyco-signatures for liver disease diagnosis ”为题在线发表于National Science Review。此外,该方法也被用于研究了正常人血清的N-完整糖肽,仅从10 μL血清中检测到了约2000条完整糖肽,系统的表征了血清完整糖肽的高异质性特点,也揭示了血清中完整糖肽的分布规律。
新闻链接:https://ibs.fudan.edu.cn/cb/40/c35420a445248/page.htm
6.脑科学研究院杨雄里院士团队揭示自感光视网膜神经节细胞在近视形成中的重要作用

复旦大学脑科学研究院/医学神经生物学国家重点实验室杨雄里院士领导的科研团队,最近对近视机制的研究取得重要进展,首次揭示了一类特殊的视网膜神经节细胞—— ipRGC(intrinsically photosensitive retinal ganglion cell)在近视形成中的重要作用,论文“The Role of ipRGCs in Ocular Growth and Myopia Development”于6月8日发表于国际权威综合性科学期刊Science Advances。
新闻链接:
https://iobs.fudan.edu.cn/df/b8/c17248a450488/page.htm
7.脑科学研究院邵志勇团队揭示肠道神经内分泌信号轴调控秀丽隐杆线虫大脑突触组装

6月24日,来自复旦大学脑科学研究院的邵志勇团队在EMBO Reports杂志上在线发表题为“Gut neuroendocrine signaling regulates synaptic assembly in C. elegans”的文章。该文章利用于秀丽隐杆线为动物模型,发现虫肠道内的Wnt-神经内分泌信号通路调控神经环(相当于脊椎动物的大脑)中神经元间的突触组装。这一项研究不仅阐明了肠道中的经典 Wnt 信号通路调控神经系统内突触形成过程的分子机制,而且揭示了肠道直接参与调控神经系统中突触装配过程中的重要作用。
新闻链接:https://iobs.fudan.edu.cn/e5/21/c17248a451873/page.htm
8.附属肿瘤医院邵志敏、胡欣、狄根红等研究团队发现三阴性乳腺癌免疫治疗新靶点

6月30日,复旦大学附属肿瘤医院乳腺外科主任兼复旦大学肿瘤研究所所长邵志敏教授、精准肿瘤中心胡欣研究员、乳腺外科狄根红教授领衔的团队,通过构建“免疫医生”文库,结合团队三阴性乳腺癌多组学研究,首次成功锁定基因“半乳糖结合凝集素2”是三阴性乳腺癌介导免疫逃逸的“帮凶”,并且有望成为三阴性乳腺癌免疫治疗新靶点,为三阴性乳腺癌的免疫治疗提供了新的方向。该项成果同日于国际权威期刊《科学·进展》(Science Advances)在线发表。
新闻链接:https://news.fudan.edu.cn/2022/0630/c40a131789/page.htm
9.附属肿瘤医院彭俊杰教授团队主持的III期肠癌中ctDNA的预后预测研究获得突破

为了证实将ctDNA与CMS分型联合是否能够更好的对III期肠癌患者进行风险分层,复旦大学附属肿瘤医院大肠综合治疗科主任彭俊杰教授团队开展了一项前瞻性、观察性的单中心研究,相关研究成果发表在European Journal of Cancer。研究团队将ctDNA、CMS分型及临床风险结合,提出了新的III期肠癌风险分层方法。
新闻链接:https://news.fudan.edu.cn/2022/0602/c40a131528/page.htm
10.附属肿瘤医院胡夕春、王碧芸、陈光亮教授团队揭示三阴性乳腺癌逃避细胞死亡的新机制

日前,附属肿瘤医院传来消息胡夕春教授、王碧芸教授、陈光亮教授团队首次发现脂肪细胞对三阴性乳腺癌铁死亡的保护作用。研究证实,与肿瘤周围脂肪细胞共培养的乳腺癌细胞显示出对铁死亡的抵抗,进一步实验发现脂肪细胞可以通过分泌特定的脂肪酸诱导乳腺癌细胞产生铁死亡抵抗,并且该过程依赖于脂肪酸合成酶ACSL3。研究团队还通过动物模型验证了脂肪细胞对三阴性乳腺癌的铁死亡保护。相关成果在排名前列的国际权威学术期刊《血液和肿瘤学杂志》在线发表。
新闻链接:https://news.fudan.edu.cn/2022/0608/c5a131593/page.htm
11.附属儿科医院黄国英教授和严卫丽教授团队SPCC队列最新成果揭示我国备孕人群叶酸营养水平普遍缺乏的现状

附属儿科医院黄国英院长和严卫丽教授团队基于SPCC队列的最新研究成果 “RBC Folate and Serum Folate, Vitamin B-12, and Homocysteine in Chinese Couples Prepregnancy in the Shanghai Preconception Cohort”于 6月9日在国际营养学领域权威学术期刊Journal of Nutrition 正式发表,该研究报道了我国备孕人群叶酸营养水平普遍缺乏的现状。
12.附属华山医院抗生素研究所胡付品研究员团队示肺炎克雷伯菌的耐药突变及药敏谱变化特征
6月11日,复旦大学附属华山医院抗生素研究所胡付品研究员团队在国际著名杂志Lancet(《柳叶刀》)在线发表了题为“The changing face of Klebsiella pneumoniae carbapenemase: in-vivo mutation in patient with chest infection(《肺炎克雷伯菌碳青霉烯酶变脸:肺部感染患者体内突变》)”的研究成果。
交叉科学领域
1.数学科学学院、智能复杂体系基础理论与关键技术实验室史际帆青年副研究员合作提出了包含细胞生灭项的细胞分化过程势能景观的分解理论

复旦大学智能复杂体系基础理论与关键技术实验室史际帆青年副研究员、东京大学合原一幸教授、北京大学数学学院李铁军教授以及中科院上海生命科学院陈洛南教授组成的研究团队,提出了包含细胞生灭项的细胞分化过程势能景观的分解理论。该理论指出了由于生灭项的影响,GRN 的复杂动力系统可以分解为两个势能项和一个非梯度项。其中细胞类型势能景观 U(x) 使用不同的亚稳态代表了不同的细胞类型;多潜能性势能景观V(x) 的数值体现了细胞的干性,并由负梯度方向表现了细胞分化的总体方向。相关研究工作在6月17日在线发表于National Science 上。
新闻链接:
https://iics.fudan.edu.cn/e2/52/c33343a451154/page.htm
2.类脑智能科学与技术研究院研究贾天野等团队揭示青春期精神行为问题的表观遗传学机制

近日,复旦大学类脑智能科学与技术研究院贾天野青年研究员、北京大学中国药物依赖性研究所的孙艳及英国伦敦国王学院的联合研究团队在 Biological Psychiatry 《生物精神病》杂志上发表题为“Associations of DNA methylation with behavioral problems, grey matter volumes and negative life events across adolescence: Evidence from the longitudinal IMAGEN study”的研究论文,对青少年时期精神行为问题相关的基于DNA甲基化的表观遗传学机制进行了多层次的探索。
新闻链接:
https://mp.weixin.qq.com/s/Y-5gu8dHvMxILmQ8iCkBiQ
3.基础医学院应天雷/吴艳玲与化学系李富友教授团队合作研发基于全人源纳米抗体的新型荧光免疫探针

近日,复旦大学基础医学院、上海市重大传染病和生物安全研究院的应天雷教授团队和复旦大学化学系李富友教授团队合作,通过将肿瘤靶向的全人源纳米抗体与近红外荧光染料吲哚菁绿定点共价偶联,建立了以全人源纳米抗体为靶向载体的新型荧光免疫探针研发平台。与传统的荧光染料相比,该类新型荧光免疫探针具有荧光信号强、检测灵敏度高、稳定性好、非侵入性可视化活体成像等显著优势,可用于转移瘤的精准成像和手术导航。相关研究成果以长文形式发表在Biomaterials上,题目为“An antigen-strengthened dye-modified fully-human-nanobody-based immunoprobe for second near infrared bioimaging of metastatic tumors”。





